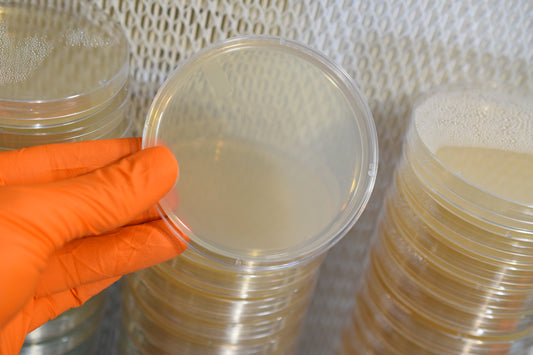
Agar Plates (10 Pack)

-
2 Jars of Grain and 5 Pounds Substrate
Regular price $57.00 USDRegular priceUnit price perSale price $57.00 USD -
Filter, Gloves, Liner - Family Fable
Regular price $1.50 USDRegular priceUnit price perSale price $1.50 USD -
2 Pounds Pasteurized Custom Blend Substrate
Regular price $15.00 USDRegular priceUnit price perSale price $15.00 USD -
5 Pounds Pastureized Custom Blend Substrate
Regular price $35.00 USDRegular priceUnit price perSale price $35.00 USD -
MYCO Induction Heater
Regular price $90.00 USDRegular priceUnit price perSale price $90.00 USD -
Agar Plates (10 Pack)
Regular price $10.00 USDRegular priceUnit price perSale price $10.00 USD